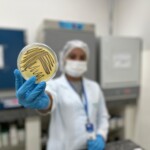
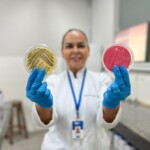
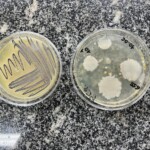

Com a chegada das festividades juninas, a movimentação nas barracas de comidas cresce exponencialmente. Para garantir a saúde dos consumidores e evitar surtos de doenças transmitidas por alimentos, o Instituto Tecnológico e de Pesquisas do Estado de Sergipe (ITPS), órgão vinculado à Secretaria do Estado do Desenvolvimento Econômico e da Ciência e Tecnologia (Sedetec), divulga orientações essenciais para os comerciantes e manipuladores de alimentos.
A contaminação pode ocorrer em qualquer etapa do processo, desde a escolha dos ingredientes até o consumo. Por isso, é importante que todos os envolvidos estejam cientes das normas e procedimentos de segurança alimentar.
A coordenadora do Laboratório de Microbiologia do ITPS, Drª Rejane Batista, enfatizou a necessidade de manter a higiene pessoal. “Lavar as mãos frequentemente com água e sabão, especialmente antes de manipular alimentos, é fundamental. Além disso, é importante utilizar uniformes limpos, manter as unhas curtas e evitar o uso de acessórios durante o preparo”, explica.
A higienização do ambiente é outro ponto que precisa ser levado a sério. Segundo a especialista, o local de preparo deve estar sempre limpo e organizado. Superfícies e utensílios precisam ser desinfetados regularmente, e os resíduos descartados corretamente para evitar o acúmulo de lixo.
A escolha dos ingredientes também são etapas que demandam atenção. “Selecionar ingredientes frescos e de qualidade, verificando sempre os prazos de validade, é essencial. Os alimentos perecíveis devem ser armazenados em temperaturas adequadas para evitar a proliferação de microorganismo como fungos e bactérias, ou alterar os aspectos físico-químicos, como cor, sabor, aroma, textura e aparência. É também importante separar alimentos crus de alimentos cozidos para prevenir a contaminação”, destacou.
Para o preparo e o cozimento, a coordenadora recomenda cuidados específicos como, cozinhar os alimentos em temperaturas adequadas para eliminar possíveis agentes patogênicos, que são organismos capazes de causar doenças infecciosas. Utilizar termômetros culinários ajuda a garantir que as carnes alcancem temperaturas seguras. Além disso, deve-se evitar o preparo de grandes quantidades de alimentos com muita antecedência, reduzindo o risco de contaminação.
O transporte e a venda dos alimentos também exigem medidas de segurança. “Transportar os alimentos em recipientes fechados e refrigerados, quando necessário, e mantê-los protegidos e em temperaturas seguras durante a venda são práticas essenciais. Oferecer utensílios descartáveis para os consumidores e evitar o manuseio direto dos alimentos são formas de minimizar os riscos”, explicou a coordenadora.
Além das práticas mencionadas, a diretora técnica do ITPS, Lúcia Calumby, ressaltou a importância de os estabelecimentos e clientes estarem atentos à qualidade dos alimentos oferecidos. “Em casos de suspeita de contaminação, é importante que o alimento seja encaminhado ao ITPS para uma análise. Assim, podemos garantir a segurança alimentar e prevenir possíveis surtos de doenças”, afirma Lúcia Calumby.
Serviço
Para solicitar os serviços do ITPS, é necessário buscar o Serviço de Atendimento ao Cliente (SAC), presencialmente na Rua Vila Cristina, bairro 13 de Julho, em Aracaju; por meio do telefone (79) 3198-8811; ou do e-mail sac@itps.se.gov.br.